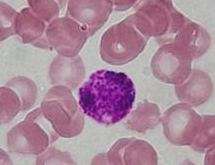

Basophil
| Basophil | |
|---|---|
|
Basophil among RBCs | |
|
Basophil | |
| Identifiers | |
| Code | TH H2.00.04.1.02022 |
A basophil is a type of white blood cell. Basophils are the least common of the granulocytes, representing about 0.5 to 1% of circulating white blood cells.[1] However, they are the largest type of granulocyte. They are responsible for inflammatory reactions during immune response, as well as in the formation of acute and chronic allergic diseases, including anaphylaxis, asthma, atopic dermatitis and hay fever.[2] They can perform phagocytosis (cell eating), produce histamine and serotonin that induce inflammation, and heparin that prevents blood clotting.[3]
Basophils were discovered in 1879 by a German physician Paul Ehrlich, who one year earlier had found a cell type present in tissues that he termed mastzellen (now mast cells).[4] Ehrlich received the 1908 Nobel Prize in Physiology or Medicine for his discoveries.
The name comes from the fact that these leukocytes are basophilic, i.e., they are susceptible to staining by basic dyes, as shown in the picture.
Structure

Basophils contain large cytoplasmic granules which obscure the cell nucleus under the microscope when stained. However, when unstained, the nucleus is visible and it usually has two lobes. The mast cell, another granulocyte, is similar in appearance and function. Both cell types store histamine, a chemical that is secreted by the cells when stimulated. However, they arise from different branches of hematopoiesis, and mast cells usually do not circulate in the blood stream, but instead are located in connective tissue. Like all circulating granulocytes, basophils can be recruited out of the blood into a tissue when needed.
Function

Basophils appear in many specific kinds of inflammatory reactions, particularly those that cause allergic symptoms. Basophils contain anticoagulant heparin, which prevents blood from clotting too quickly. They also contain the vasodilator histamine, which promotes blood flow to tissues. They can be found in unusually high numbers at sites of ectoparasite infection, e.g., ticks. Like eosinophils, basophils play a role in both parasitic infections and allergies.[5] They are found in tissues where allergic reactions are occurring and probably contribute to the severity of these reactions. Basophils have protein receptors on their cell surface that bind IgE, an immunoglobulin involved in macroparasite defense and allergy. It is the bound IgE antibody that confers a selective response of these cells to environmental substances, for example, pollen proteins or helminth antigens. Recent studies in mice suggest that basophils may also regulate the behavior of T cells and mediate the magnitude of the secondary immune response.[6]
CD200
Basophil function is inhibited by CD200. Herpesvirus-6, herpesvirus-7, and herpesvirus-8 produce a CD200 homolog which also inhibits basophil function. This suggests that basophils may play a role in the immune response to these viruses.[7]
Immunophenotyping of basophils
Basophils of mice and humans have consistent immunophenotypes, including FcεRI+, CD123, CD49b(DX-5)+, CD69+, Thy-1.2+, 2B4+, CD11bdull, CD117(c-kit)−, CD24−, CD19−, CD80−, CD14−, CD23−, Ly49c−, CD122−, CD11c−, Gr-1−, NK1.1−, B220−, CD3−, γδTCR−, αβTCR−, α4 and β4-integrin negative.[8]
Recently, Heneberg[9] proposed that basophils may be defined as the cellular population positive for CD13, CD44, CD54, CD63, CD69, CD107a, CD123, CD164, CD193/ CCR3, CD203c, TLR-4, and FcεRI. When activated, some additional surface markers are known to be upregulated (CD13, CD107a, CD164), or surface-exposed (CD63, and the ectoenzyme CD203c).[9]
Secretions
Basophils arise and mature in bone marrow. When activated, basophils degranulate to release histamine, proteoglycans (e.g. heparin and chondroitin), and proteolytic enzymes (e.g. elastase and lysophospholipase). They also secrete lipid mediators like leukotrienes (LTD-4), and several cytokines. Histamine and proteoglycans are pre-stored in the cell's granules while the other secreted substances are newly generated. Each of these substances contributes to inflammation. Recent evidence suggests that basophils are an important source of the cytokine, interleukin-4, perhaps more important than T cells. Interleukin-4 is considered one of the critical cytokines in the development of allergies and the production of IgE antibody by the immune system. There are other substances that can activate basophils to secrete which suggests that these cells have other roles in inflammation.[10]
The degranulation of basophils can be investigated in vitro by using flow cytometry and the so-called basophil-activation-test (BAT). Especially, in the diagnosis of allergies including of drug reactions (e.g. induced by contrast medium), the BAT is of great impact.[11]
Basopenia (a low basophil count) is difficult to demonstrate as the normal basophil count is so low; it has been reported in association with autoimmune urticaria[12] (a chronic itching condition). Basophilia is also uncommon but may be seen in some forms of leukaemia or lymphoma.
Etymology and pronunciation
The word basophil (/ˈbeɪsəˌfɪl, -z-, -oʊ-/[13][14]) uses combining forms of baso- + -phil, yielding "base-loving".
References
- ↑ "Blood differential test". Medline Plus. U.S. National Library of Medicine. Retrieved 22 April 2016.
- ↑ Mukai, K; Galli, SJ (2013). "Basophils". ELS. Online. doi:10.1002/9780470015902.a0001120.pub3. ISBN 0470016175.
- ↑ Khurana (2009). Textbook Of Medical Physiology (2nd ed.). Elsevier. p. 180. ISBN 978-81-8147-850-4.
- ↑ Blank, U.; Falcone, F. H.; Nilsson, G. (2013). "The history of mast cell and basophil research - some lessons learnt from the last century". Allergy. 68 (9): 1093–1101. doi:10.1111/all.12197. PMID 23991682.
- ↑ Voehringer D (December 2009). "The role of basophils in helminth infection". Trends Parasitol. 25 (12): 551–6. doi:10.1016/j.pt.2009.09.004. PMID 19782643.
- ↑ Nakanishi, Kenji (December 2010). "Basophils as APC in Th2 response in allergic inflammation and parasite infection". Current Opinion in Immunology. 22 (6): 814–820. doi:10.1016/j.coi.2010.10.018. PMID 21095110.
- ↑ http://www.jimmunol.org/content/175/7/4441.short
- ↑ Schroeder JT (2009). "Basophils beyond effector cells of allergic inflammation". Adv Immunol. Advances in Immunology. 101: 123–161. doi:10.1016/S0065-2776(08)01004-3. ISBN 9780123747938. PMID 19231594.
- 1 2 Heneberg, Petr (2011). "Mast cells and basophils: trojan horses of conventional lin- stem/progenitor cell isolates". Current Pharmaceutical Design. 17 (34): 3753–3771. doi:10.2174/138161211798357881. PMID 22103846.
- ↑ Janeway CA Jr.; et al. (2001). Immunobiology. (electronic full text via NCBI Bookshelf) (5th ed.). Garland Publishing. ISBN 0-8153-3642-X.
- ↑ Böhm I, Speck U, Schild HH (April 2011). "Pilot study on basophil activation induced by contrast medium". Fundam Clin Pharmacol. 25 (2): 267–76. doi:10.1111/j.1472-8206.2010.00826.x. PMID 20412314.
- ↑ Grattan CE, Dawn G, Gibbs S, Francis DM (Mar 2003). "Blood basophil numbers in chronic ordinary urticaria and healthy controls: diurnal variation, influence of loratadine and prednisolone and relationship to disease activity". Clin Exp Allergy. 33 (3): 337–41. doi:10.1046/j.1365-2222.2003.01589.x. PMID 12614448.
- ↑ "basophil". Merriam-Webster Dictionary. Retrieved 2016-01-21.
- ↑ "basophil". Oxford Dictionaries. Oxford University Press. Retrieved 2016-01-21.
Additional images
-

Blood cell lineage
-
Alternate stain of a basophil
External links
| Wikimedia Commons has media related to basophils. |
